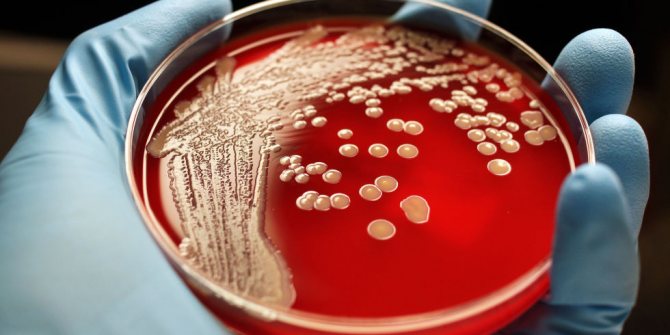
image

Согласно статистическим исследованиям, носителями стафилококковой инфекции является 13 населения планеты. При условии сильного иммунитета у человека колония микроорганизмов может на протяжении всей жизни обитать на его коже, на слизистой носоглотки, в ЖКТ и никак не проявить себя. Однако стоит иммунной системе ослабеть и бактерии начнут активно размножаться, вызывая как легкие недомогания, так и тяжелые патологии.
Несмотря на то что стафилококки являются возбудителями десятков заболеваний, среди врачей нет единого ответа на вопрос о том, надо лечить инфекцию стафилококка или нет. Часть медиков утверждает, что лечение необходимо даже в случае, если бактерии никак себя не проявляют, т.к. это обезопасит пациента в будущем.
Однако другие утверждают, что начинать терапию следует только в случае развития заболевания, а лечить стафилококковую инфекцию при крепком иммунитете и пассивности бактерий нельзя, т.к. микроорганизм отличается высокой резистентностью (устойчивостью) ко многим видам антибиотиков, которые придется применять. Под их воздействием полезная микрофлора, поддерживающая сопротивляемость организма, быстро гибнет, а стафилококки могут не только не погибнуть, но и получить улучшенные условия для размножения и повысить резистентность.
Что такое стафилококк и какая его предельная норма в носу?
Стафилококки относятся к ряду грамположительных бактерий.
Они распространены повсеместно в окружающей среде, и имеют высокую степень устойчивости, к внешним факторам сохраняя свою активность даже без доступа воздуха и при замораживании.
У 80% людей стафилококк постоянный обитатель кожных покровов, только 20% населения обладают специфическим иммунитетом, который не позволяет бактериям обосноваться на слизистой оболочки носа.
Норма стафилококка в носовой полости при выполнении бактериального посева составляет 10 во второй степени или 10 в 3 степени КОЕ/мл.
Пути передачи инфекции
Золотистый стафилококк является самым агрессивным представителем этого вида микроорганизмов. Причиной очень многих опасных заболеваний является именно золотистый стафилококк. Как передается инфекция? Источником могут стать медицинские инструменты, которые были плохо обработаны, внутривенное питание.
Развиваться инфекция может начать после ряда перенесенных болезней, которые ослабили иммунитет. К ним относятся грипп, ОРВИ, травмы, дисбактериоз. Возможно прогрессирование после хирургического вмешательства или различных медицинских процедур.
Довольно часто инфекция размножается на продуктах питания. Вместе с пищей она проникает в организм человека. Обычно появляется на сладкой продукции, мясе, яйцах, молочной продукции. Энтеротоксин инфекции несет огромную опасность для организма, так как способен вызвать тяжелые отравления. После этого появляются сильные боли в животе, рвота, диарея.
Разновидности
В настоящее время различаются более 20 видов стафилококка. Но для человека особую опасность представляют три разновидностей из этого списка.
Ими являются:
- Золотистый стафилококк. Является причиной множества заболеваний организма с тяжёлыми последствиями. Возникший насморк при отсутствии адекватной терапии может вызывать пневмонию или менингит. Свое название “золотистый” он получил в силу своих способностей вырабатывать золотистый пигмент. Основной характеристикой этой формы стафилококка является устойчивость к большинству видов антибактериальных препаратов. Лекарственные средства группы Пенициллинового и Цефалоспоринового ряда крайне плохо справляются с этой инфекцией, так как патогенные возбудители быстро приобретают устойчивость, и дальнейшая терапия этими лекарствами становится бесполезной.
- Вид сапрофитного стафилококка. Имеет особенность поражать органы урогенитального тракта, вызывая процесс воспаления мочевого пузыря и мочеточников (Цистит или Уретрит).
- Эпидермальная разновидность стафилококка. Основное место обитания кожная поверхность, из-за чего становится причиной инфицирования открытых ран. При попадании в зрительные органы вызывает конъюнктивит, также может быть причиной болезни мочеполовой системы, а при проникновении в системный кровоток способствует развитию сепсиса (заражение крови). Особая опасность этой разновидности возбудителя заключается в том, что он действует как гемолитический стафилококк, и способен поражать сердечную мышцу вызывая эндокардит.
Стафилококк: описание и виды
Под микроскопом стафилококковая инфекция выглядит как неподвижное тело шарообразной формы. В мазке бактерии располагаются в виде гроздевидных скоплений. Среди всех остальных разновидностей, насчитывающих 27 видов, опасность для человека представляют лишь 3:
- Стафилококк Ауреус, или золотистый (золотой) стафилококк, являющийся наиболее вредным.
- Стафилококк Эпидермидис, также являющийся патогенным, но менее опасным для организма.
- Стафилококк Сапрофитикус, считающийся безвредным, но при благоприятных условиях все же способный вызвать заболевание.
Золотистый стафилококк наиболее опасен для здоровья. Этот вид кокков способен жить и размножаться как при доступе кислорода, так и в его отсутствие. Жизненную энергию он получает от процессов брожения и окисления. Микроорганизмы отличаются повышенной устойчивостью к солнечному свету, заморозке, нагреванию, многим химическим веществам. Бактерии можно убить только воздействием перекиси водорода или длительным кипячением. Устойчивость к большинству антибиотиков и дезинфицирующих средств ставит стафилококки в разряд крупных проблем медицины.
Попадая в организм с пониженной сопротивляемостью, стафилококковая инфекция быстро проникает в плазму крови и разносится по всем органам. Параллельно происходит активная выработка ферментов и токсинов, способствующих развитию инфекционно-воспалительных процессов:
- гемолизины оказывают мощное иммунноподавляющее воздействие и повышают выживаемость стафилококков в очагах воспалений;
- эксфолиатины разрушают клетки кожи;
- лейкоцидины уничтожают лейкоциты;
- фибринолизин способствует развитию сепсиса;
- энтеротоксины вызывают сильное пищевое отравление.
Причины возникновения
Стафилококки окружают человека повсюду. Они присутствуют:
- на коже носителей;
- в продуктах питания;
- в воздушной среде;
- на предметах быта.
По причине широкой распространенности заразиться инфекцией можно:
- контактно-бытовым путем;
- воздушно-пылевым;
- воздушно-капельным;
- пищевым.
Передача стафилококка может происходить:
- через рукопожатие с носителем;
- при контакте с грязными поверхностями (поручнями в транспорте, деньгами, банкоматами);
- в результате употребления в пищу немытых продуктов;
- при несоблюдении правил личной гигиены и дезинфекции в медучреждениях;
- в среде наркоманов через грязную посуду и общие шприцы для инъекций;
- от инфицированной матери к ребенку, находящемуся на грудном вскармливании или еще в период внутриутробного развития.
Опасность заражения увеличивается на фоне ослабления защитных функций организма, которые могут быть спровоцированы:
- переутомлением;
- стрессом;
- плохим питанием;
- травмами кожных покровов;
- рядом хронических и острых заболеваний, таких как сахарный диабет, нарушение эндокринной системы, ОРВИ;
- гиповитаминозом;
- перегреванием или, наоборот, переохлаждением;
- злоупотреблением антибиотиками;
- длительным приемом гормональных препаратов;
- длительной химиотерапией.
Более уязвимыми перед инфекцией золотистого стафилококка являются:
- пожилые люди;
- ВИЧ-инфицированные и больные СПИДом;
- онкобольные;
- люди, страдающие тяжелой формой астмы;
- пациенты, перенесшие трансплантацию органов.
Признаки
Первичное заражение происходит через кожу, дыхательные пути и ЖКТ. Распространение заболевания в легкие, кости, суставы, мозг всегда вторично. Стафилококковая инфекция кожи проявляется в виде:
- фурункулеза;
- панариций — нагноений мягких тканей пальцев;
- абсцесса — гнойного воспаления мягких тканей;
- флегмоны — разлитого гнойного поражения мягких тканей, сопровождающегося некрозом.
Развитие этих патологий происходит достаточно быстро и сопровождается:
- покраснением и нагноением пораженного участка;
- повышением температуры;
- болевым синдромом;
- образованием болезненных нарывов, в тяжелых случаях происходит отмирание кожных покровов.
Наиболее опасными являются очаги заболевания на лице и голове, проявляющиеся в виде гнойных нарывов.
У новорожденных детей заражение стафилококком проявляется в виде фурункулеза, фолликулита, флегмоны или пузырчатки — патологии, при которой кожа ребенка покрывается сыпью и очагами покраснения. В этих очагах кожа отслаивается пластами, а под ними надуваются пузыри.
Симптомами стафилококковой инфекции в носу являются:
- резкое повышение температуры;
- насморк;
- обильные выделения из носа (прозрачные или гнойные сопли);
- отек носоглотки;
- покраснения в местах поражения.
Корки в носу и болезненные гнойные высыпания снаружи и внутри носа также являются признаками инфицирования стафилококком, однако необязательным.
Стафилококковая инфекция в горле чаще встречается у детей и проявляется в виде острого фарингита или тонзиллита. Симптомами заболевания являются:
- острая боль в горле;
- отечность;
- ощущение боли при глотании;
- сплошной налет белого или желтого цвета на миндалинах, который легко снимается;
- лихорадка;
- сильное покраснение неба, миндалин, стенок, свода, гортани.
Возможные пути заражения
После проникновения стафилококка в организм для его развития необходимо наличие следующих условий:
- Большое количество микроорганизмов, которые сопровождается активным ростом.
- Снижение защитной функциональности организма человека.
- Наличие “входных ворот” для бактериального патогена. Этому причиной может быть открытая раневая поверхность, небольшие ссадины, или повреждение слизистой носа в результате неудачного его очищения.
Основными путями заражения принято считать следующие ситуации:
- По воздуху. Самый часто встречаемый и быстрый путь распространения стафилококка. Заражение может происходить при вдыхании воздуха от инфицированного больного через нос или ротовую полость. Это становится возможным при посещении мест с повышенной скученностью у населения (больницы, общественный транспорт, школы и детские сады).
- Контактный путь инфицирования имеет место, когда нарушается личная гигиена. Это может происходить при использовании предметов косметики или личность вещей. Не редкими бывают случаи передачи инфекции при рукопожатии или передачи денег, так как на их поверхности находится много бактериальной инфекции.
- Особенно часто происходит заражение золотистым стафилококком в условиях родильного дома, при этом ребенок может инфицироваться во время родов, проходя по естественным родовым путям матери. Частыми являются случаи передачи инфекции при кормлении грудничка молоком.
- У людей повышается риск заражения, если они пренебрегают правилами термической обработки пищевых продуктов.
- Провоцировать развитие стафилококка в носу могут длительные заболевания, которые приводят к снижению иммунного статуса организма. Это может происходить как следствие переохлаждения организма (например, когда человек попадает под холодный дождь, и сильно промокает).
- Частой причиной может служить бездумное применение антибактериальных препаратов, как таблетированных, так и в форме назальных капель.
Методы диагностики
Основным методом диагностики стафилококка является лабораторное исследование мазка, взятого из носа, горла, реже с поверхности кожи. Иногда возникает необходимость в более детальном или узконаправленном исследовании, тогда врач дает направление на анализ:
- крови;
- мокроты;
- мочи;
- кала;
- грудного молока;
- содержимого ушей;
- выделений цервикального канала у женщин и др.
Целью исследования является определение рода и вида возбудителя. Исследования проб проводят только в баклабораториях, оснащенных специальным оборудованием.
Бактериологическое исследование требует специальной подготовки. Примерно за неделю до сдачи анализа или мазка необходимо отказаться от курения, приема спиртного, антибиотиков (в том числе и местного применения), противовирусных препаратов.
Анализ крови и мазок сдаются утром на голодный желудок. Перед сдачей мазка необходимо хорошо вычистить зубы, высморкаться и прополоскать горло. Это необходимо сделать, чтобы получить максимально достоверную, ничем не смазанную картину заболевания.
Мазок берется при помощи стерильной ваты и медицинского пинцета. Взятый образец следует как можно быстрее поместить в пробирку с питательной средой и плотно закупорить. Через несколько дней вирус размножится и по количеству выросших колоний можно будет судить о том, насколько сильно поражен организм и требуется ли лечение.
Однако на этом исследование не заканчивается. Т. к. стафилококк проявляет повышенную устойчивость к антибиотикам и противовирусным препаратам, лаборант обязательно проводит исследование на резистентность пробы к различным видам лекарственных средств.
Результат анализа представляет собой бланк, на котором указаны нормы и фактическое количественное содержание колоний в пробе и перечень антибиотиков, к которым микроорганизм проявил устойчивость или чувствительность.
Если проба выявила количество колоний, равное 103 , это означает, что человек является носителем, но лечение не требуется. Если показатели превысили значение 104 , то лечение необходимо.
В списке препаратов лаборант отмечает латинской буквой:
- S (susceptible) препараты, к которым микроорганизм проявил чувствительность.
- I (intermediate) — умеренную чувствительность.
- R (resistant) — резистентность, т. е. устойчивость.
Медикаментозное лечение
Лечением стафилококковой инфекции занимается профильный врач, т. е. тот, в ведении которого находится пораженный орган (лор, гинеколог, гастроэнтеролог и т.д.).
Основной принцип лечения заключается в подборе антибиотика, к которому вирус проявил наибольшую чувствительность, и которым пациент не пользовался последние несколько лет. При поражениях кожи обходятся антибактериальными мазями, такими как Фузидерм или Банеоцин. Однако при инфицировании внутренних органов, в т. ч. и носоглотки, назначают лекарства для приема внутрь, наиболее эффективными являются:
- Амоксициллин.
- Амоксислав.
- Оспексим.
- Бисептол.
- Клиндамицин.
- Ориприм.
Негативной стороной лечения антибиотиками является уничтожение не только болезнетворной, но и полезной микрофлоры. Кроме того, антибиотики необходимо принимать по строгой схеме, нарушение которой уничтожит достигнутые результаты и выработает резистентность у микроорганизмов.
Кроме антибиотиков, в схемы лечения входят и другие препараты. Обязательным является прием иммуномодуляторов, быстро купирующих внешнее проявление заболевания. Под их воздействием растет сопротивляемость организма, что предотвращает возможность рецидива.
При лечении инфекции горла и носа не обойтись без капель, спреев и мазей, предназначенных для обработки пораженных поверхностей. Хорошо зарекомендовали себя такие средства, как:
- Диоксидин.
- Изофра.
- Септисол.
- Хлорофиллипт.
- Имудол.
- ИРС-19.
Среди иммуностимуляторов при лечении верхних дыхательных путей и глотки эффективными являются Бронхо-Мунал и Бронхо-Ваксом.
Народные рецепты
Народная медицина предлагает множество рецептов, предназначенных для борьбы с инфекциями стафилококка в носоглотке и укрепления иммунитета. К ним относятся:
- Травяные отвары и настойки. Популярным и эффективным средством является сбор из травы калгана, корня аира, корня окопника, травы девясила, цветков календулы и листьев подорожника. Травы смешивают в равных пропорциях, берут 1 ст. л. смеси, заливают 0,5 л воды и варят на медленном огне на протяжении 15 минут, затем переливают в термос и настаивают несколько часов. После этого настойку процеживают и принимают 3 раза в сутки за 30 минут до еды по 100 г на протяжении 10-15 дней.
- Прополис обладает мощными антибактериальным, антивирусным, противовоспалительным и восстановительным действиями. Его рекомендуется принимать в виде спиртовой настойки, добавляя в растворы для полоскания горла и промывания носовых ходов.
- Эфирные масла, обладающие антибактериальным воздействием и рекомендованные к приему как внутрь, так и для полосканий и санации полостей носа и рта. Наиболее эффективными при лечении стафилококка в носу являются масла:
- тмина ползучего;
- мяты перечной;
- розмарина.
- Смородиновый сок, обладающий мощным иммуномодулирующим эффектом (из-за присутствия специфических фитонцидов). При его ежедневном употреблении резко снижается вероятность распространения инфекции на внутренне органы и повторного заражения.
- Яблочный уксус, дающий хороший лечебно-профилактический эффект при приеме внутрь вместе с соком смородины.
Лечение стафилококка у детей и грудничков
Грудные дети чаще всего заражаются стафилококком в родильных отделениях в процессе кормления, если мать больна маститом, реже — через кровь или кожу из-за использования нестерильного медицинского инвентаря. Чаще всего страдают кожные покровы. Заражению больше подвержены дети недоношенные, с врожденными патологиями и ослабленным иммунитетом. Лечение включает применение антибиотиков и иммуномодуляторов, призванных поднять защитные функции организма и заставить его самостоятельно противостать инфекции.
При пониженном иммунитете у детей заражение может происходить и в более старшем возрасте и захватывать не только кожные покровы или носоглотку, но и перерастать в более тяжелые патологии, такие как:
- стафилококковая пневмония;
- скарлатиноподобный синдром;
- стафилококковый гастроэнтерит.
Все заболевания относятся к разряду тяжелых, развиваются быстро, протекают на фоне резкого ухудшения самочувствия, высокой температуры, образования гнойных воспалений, потери аппетита, расстройства функций дыхания и кишечника, слабости, головокружения и т. д. Лечение требует немедленной госпитализации, т.к. не исключен летальный исход.
Стафилококк при беременности
В период беременности организм будущей матери более уязвим, что повышает вероятность заражения и инфицирования плода. Чаще всего у беременных обнаруживаются такие виды стафилококков, как:
- сапрофитный;
- эпидермальный;
- гемолитический;
- золотистый.
Наименее опасным для матери и ребенка является стафилококк сапрофитный, локализующийся в области мочеполовой системы и провоцирующий уретриты, нефриты и циститы. Гемолитический вид инфекции часто активизируется в период беременности и вызывает тонзиллит.
Золотистый и эпидермальный стафилококки являются самыми опасными, т. к. могут вызвать заболевания, чреватые смертью и плода, и матери. Первый провоцирует у матери воспаления легких, брюшины, мозговых оболочек, мастит, фурункулез, а у плода — пузырчатку. Второй может стать причиной развития эндокардита и сепсиса, в результате которых повышается возможность летального исхода как для женщины, так и плода.
Чтобы избежать развития инфекций, сразу после постановки на учет женщина должна пройти обследование на наличие патогенной микрофлоры и вместе с лечащим врачом принять соответствующие защитные меры.
Если инфекция выявлена в носу, ее лечат при помощи санации носоглотки противовирусными препаратами, применения бактериофагов и иммуномодуляторов.
При первых симптомах инфицирования рекомендуется немедленно начать промывание носоглотки теплым солевым раствором с интервалом не более 3 часов и как можно быстрее обратиться к врачу. А с целью профилактики женщина должна:
- сбалансировано питаться;
- регулярно проветривать помещение и бывать на свежем воздухе;
- неукоснительно соблюдать правила личной гигиены.
Симптомы клинической картины при проникновении стафилококка в полость носа
Практически каждый человек имеет определенное количество стафилококковой инфекции, которая локализуется в области носа, ротовой полости и глотки. Но при этом она не вызывает развития патологий. Ослабление иммунной защиты или травматические повреждения активизируют рост патогенной микрофлоры.
В силу этого у человека появляется следующие признаки симптомокомплекса патологического процесса:
- Появляется частое чиханье с выделением прозрачного слизистого секрета, который постепенно становится грязно желтого цвета из-за наличия гнойного содержимого.
- Возникает заложенность носовых ходов. Из-за чего пациент вынужден производитель вдох и выдох через рот.
- Утрачивается способность различать запахи и вкус пищи.
- Появляется гнусавость и осиплость как следствие изменения тембра голоса.
- Острое начало может сопровождаться увеличением температурного показателя тела до 38 градусов, осложненная форма может приводить к повышению температуры до критических отметок (больше 39 градусов).
- Упадок сил может вызывать чувство усталости даже при выполнении обычной работы по дому. При этом пациенты часто жалуются о расстройстве ночного сна.
- Стремительное развитие может переносить воспалительный процесс в придаточные пазухи носа с последующим развитием гайморита или фронтита.
- В детском возрасте нередко появление кожных высыпаний на теле.
- Тяжёлые случаи сопровождаются появлением гнойничковых высыпаний в области носа. По мере созревания они лопаются и создают влажную поверхность с последующим образованием золотистых корочек.
Наличие проблемы при беременности
Всем женщинам, вставшим на учет по беременности, назначается сдача мазка на стафилококк.
Выявление повышенного содержания микроорганизмов является поводом для начала полноценного лечения, поскольку выделяемые бактериями токсины могут негативно сказаться на состоянии плода.
Но при этом каждое лекарство для будущих мамочек подбирается с особой щепетильностью, причем предпочтение стараются отдавать средствам для местного применения.
Поскольку основной причиной того, от чего у беременных активизируется условно-патогенная микрофлора, является снижение иммунитета, им всегда советуют:
- больше гулять на свежем воздухе;
- принимать витамины;
- полноценно питаться.
Таким образом, причин, откуда появляется грибок в носу, уйма, но при этом говорить о том, заразно ли это не приходится. Ведь каждый человек может быть носителем того или иного вида этой бактерии, даже не догадываясь об этом.
В каждом отдельном случае, чем вылечить инфекцию, следует решать индивидуально, причем выбор тактики и направления терапии стоит доверять только квалифицированному ЛОРу, чтобы не усугубить сложившегося положения.
То, как выглядит стафиллококк в носу вы можете посмотреть на фото, расположенные выше в статье.
Особенности диагностики
Данную разновидность инфекции необходимо дифференцировать с проникновением стрептококков, гемофильной палочки или пневмококков. Эта патогенная микрофлора может вызывать похожие симптомы и клинические проявления.
Идеальным вариантом для постановки точного диагноза является проведение бактериального посева, материал для которого берется из полости носа.
Но существует один нюанс, который следует учитывать. Бактериальный посев это вид лабораторного исследования, который занимает несколько дней. Стафилококковая инфекция имеет тенденцию быстрого развития, и может стать причиной появления тяжелых осложнений, которые будут представлять больший вред для организма, чем болезнь слизистой носа.
Поэтому для подтверждения диагноза берется мазок из полости носа для проведения иммуноферментного анализа.
Кроме этого назначаются дополнительные лабораторные исследования для установления остроты процесса:
- Общий клинический анализ крови.
- Исследование мочи.
Взятие бактериального посева происходит с одновременным определением чувствительности стафилококка на антибактериальные препараты.
Симптомы
Заразиться можно от инфицированного человека, в больничном стационаре, роддоме и другом медучреждении. Нос и его полости – одно из любимых мест этого возбудителя. Подозрение на стафилококковую инфекцию могут вызывать следующие симптомы:
- Гиперемия слизистой;
- Насморк и заложенность;
- Высокая температура и сильная интоксикация, недомогание, что может стать причиной тяжелого состояния взрослого и ребенка;
- Характерная особенность – гнойнички, воспаление участков кожи преддверия носа.
В носу возбудитель может стать причиной гайморита, насморка и отита.
Опасность стафилококка в носу
Опасность этого инфекционного патогена заключается в его быстром перемещении по организму пациента.
Если отсутствует терапия по каким-либо причинам, или лечебные мероприятия производится не в полном объеме, то в первую очередь инфекция распространяется на следующие органы:
- Легкие и ротоглотку. В этом случае увеличивается шанс развития пневмонии, трахеита или воспалительного процесса в небных миндалинах.
- Проникая в придаточные пазухи носа, возникает гайморит, фронтит или синусит.
Самые опасные проявления стафилококка:
- Эндокардит. Поражение внутреннего слоя сердца (эндокарда). Чаще всего происходит одновременное поражение оболочки сердца с митральным или аортальным клапаном.
- Менингит. Гнойное воспаление с местом локализации в менингеальной оболочке головного мозга. Болезнь чаще всего является последствием проникновения золотистого стафилококка.
- Токсический шок. Может стать последствием операбельной терапии в полости носа, нередко отмечаются случаи возникновения после родов. В этой ситуации у пациента появляется скачкообразное повышение температуры тела до 40 градусов, которая происходит на фоне понижения артериального давления. В воспалительный процесс вовлекается легочная ткань и другие, жизненно важные органы.
- Общее заражение крови в форме сепсиса. Опасность этой патологии заключается в способности формировать очаги воспаления в кишечнике, печени, легочной ткани и в головном мозге. В детском возрасте может стать причиной летального исхода ребенка.
Возможные осложнения
Стафилококк в носу может привести к серьезным нарушениям здоровья, а в тяжелых случаях стать причиной гибели пациента. Бактерии проникают в нижние дыхательные пути, через руки переносятся по всему телу, а пи попадании в мельчайшие раны попадают в системный кровоток. Такое состояние (при отсутствии лечения) заканчивается септическим шоком и гибелью больного.
При неполном лечении, инфекция переходит в хроническую форму, поражая иммунную системы, и напоминая о себе с периодичностью 2-3 раза в год.
Обнаруженные микробы в полости носа и зева усугубляют течение заболевания, вызывают различные осложнения и затрудняют лечение недуга.
Обзор медикаментозных средств, которые назначаются для терапии стафилококка в полости носа
Применение лекарственных средств, при развитии этой патологии требует индивидуального подхода, для чего пациенту необходимо обратиться в медицинское учреждение на прием к врачу терапевту.
Такая необходимость возникает из-за стремительного течения болезни, в результате чего, промедление может привести к нежелательным последствиям (особенно в детском возрасте).
Применение капель и назальный спреев при стафилококке в носовых проходах
Для местного применения используются следующие виды антибактериальных средств:
- Изофра. Лечебная эффективность обусловлена наличием основного ингредиента Фрамицетина. Оказывает губительное действие на стафилококковую инфекцию. Основным достоинством препарата следует считать большой спектр действия (кроме стафилококков, угнетающе действует на стрептококковую микрофлору). Высокая эффективность позволяет избавиться от негативной симптоматики стафилококка за 10-дневный курс лечения.
- Диоксидин. Удачная комбинация антисептика и антибиотика в одном препарате. Правильно произведенная терапия обеспечивает быстрое выздоровление не вызывая раздражение слизистого эпителия носа. Большим плюсом является то, что способен быстро нейтрализовать гнойные выделения из носовых ходов. Отрицательной стороной препарата является невозможность применения в детском возрасте до 12 лет, и у женщин которые ожидают рождения ребенка.
- Септисол. Антибактериальная эффективность обеспечивается ингредиентами природного происхождения (Живица, Мумиё и Каменевое масло). Параллельно с антибактериальным и антисептическим действием обладает обезболивающим эффектом. Основное преимущество состоит в том, что не воздействует на полезную микрофлору. Из-за малой токсичности разрешается применять женщинам, которые находятся в любом триместре беременности, и в период, когда происходит кормление малыша грудным молоком. Из-за присутствия природных компонентов в некоторых случаях возможно развитие аллергии.
Изофра
Диоксидин
Септисол
Антибактериальные препараты для системного применения
Даная инфекция имеет особенность постоянной мутации, что приводит к возникновению резистентной формы золотистого стафилококка. Это вызывает определенные затруднения при выборе антибактериального препарата.
Чтобы подавить развитие этой патогенной микрофлоры используют следующие виды антибактериальных средств:
- Кларитромицин. Является ярким представителем группы Макролидов. Терапевтическое действие заключается в его проникновении внутрь инфекционного патогена, после чего он оказывает разрушающее действие на внутриклеточное ядро. Большой охват действия на бактериальные возбудители позволяет его применять при развитии ларингита, ринита или когда происходят кожные высыпания. В любом триместре беременности данное средство принимать нежелательно.
- Амоксициллин. Антибактериальное средство Пенициллинового ряда. Применяется в качестве терапии последствия стафилококковой инфекции. Чаще всего при развитиисепсиса. Не назначается если основные или дополнительные ингредиенты являются аллергеном для пациента. Не допускается использование в любом триместре беременности.
- Азитромицин. Представляет фармакологическую группу Азалидов. Хорошо справляется с проявлениями болезни, которая локализуется в области носа и ротоглотки. Лечебная эффективность основана на подавление белковых фракций внутри патогенных микроорганизмов. Не допускается использование во время грудного кормления малыша, при беременности кратность применения и длительность курса устанавливается врачом.
- Ципрофлоксацин. Относится к фармакологической группе Фторхинолонов. Из этого ряда считается самым часто применяемым лекарственным средством. Может применяться в случае поражения стафилококками зрительных органов. Не назначается лицам, которые не достигли 18 летнего возраста. Беременность и кормление грудью является полным противопоказанием.
- Ванкомицин. Лекарственная форма, принадлежащая к фармакологической группе Гликопептидов. Оказывает губительное действие на стафилококковую стрептококковую микрофлору. Но из-за особенности вызывать тяжелые аллергические проявления, первый прием препарата должен происходить под контролем врача. Полным ограничением сферы применения этого лекарственного средства является дисфункция почек и сбой в работе печени. Препарат не назначается в любом триместре беременности, людям преклонного возраста и новорождённым.
Амоксицилин
Азитромицин
Ципрофлоксацин
Кларитромицин
Ванкомицин
Чем лучше всего обрабатывать полость носа при возникновении стафилококка?
Чтобы создать препятствия для размножения патогенной микрофлоры используется следующие разновидности препаратов:
- Хлорофиллипт. Помимо уничтожения стафилококков, обладает регенерирующим действием на слизистую оболочку, которая выстилает внутреннюю поверхность носа или горла. Особая эффективность отмечена, если раствор наносится на небольшую ватную турунду, которая размещается в просвете носовых проходов, или при обработке миндалин. Это манипуляцию разрешается проводить детям, предварительно разбавив раствор растительным маслом.
- Раствор бриллиантовой зелени (Зеленка). Обработку следует проводить только с наружной части носа, это позволит избежать ожога слизистой оболочки, в результате чего может появляться чувство жжения.
- Стафилококковый бактериофаг. В его составе присутствуют особые вирусы-фаги. Они способны уничтожать золотистый стафилококк даже в тех случаях, когда он устойчив к антибактериальным средствам. Его применение не сопряжено с развитием побочных эффектов, также он не имеет противопоказаний. Для удобства в использовании рекомендуется применять в виде аппликаций (небольшая ватная турунда вводится в полость носа). Длительность терапии составляет от 7 до 10 дней.
- Перекись водорода. Перед применением разводится чистой водой или Натрием хлорида (соотношение 1 к 11). Пациенты отмечают особую эффективность при возникновении гнойничковых высыпаний.
Хлорофиллипт
Перекись водорода
Зеленка
Стафилококковый бактериофаг
Дополнительная терапия с применением иммуномодуляторов
Иммуномодуляторы позволяют восстановить естественные силы организма и повысить сопротивляемость к возникшей инфекции.
Особо эффективностью отличается:
- Капли для назального применения ИРС-19.
- Иммунал.
- Циклоферон, применяются в форме внутримышечных инъекций по схеме.
ИРС 19
Циклоферон
Иммунал
Когда необходимо обратиться к врачу
При первых проявлениях заболеваний, вызванных действием стафилококка, нужно обратиться в медицинское учреждение. На начальном этапе обследования необходима консультация терапевта, который в зависимости от сопутствующих симптомов, выдаст направление на прием к отоларингологу, инфекционисту или иммунологу.
Консультация отоларинголога необходима в случае наличия следующей симптоматики:
- длительное течение насморка;
- повышение температуры тела;
- смена цвета прозрачных или желтоватых выделений из носа на желто-коричневый или зеленый;
- общее недомогание;
- боли в области носовых пазух.
Помимо назначений бактериологических анализов, отоларинголог направит на дополнительные методы исследования – рентген пазух носа или грудной клетки. Консультация иммунолога нужна в случае, когда стафилококковая инфекция вызвана снижением активности иммунной системы.
Рецепты народного врачевания
Альтернативная медицина даёт позитивную динамику в терапии стафилококка, если она назначается комплексно, и перед этим пациент консультируется с доктором.
Это обуславливается тем, что природные компоненты создают возможность развития аллергических реакций.
Рецепты народного врачевания, которые назначаются чаще всего:
- Для поднятия функциональности защитного барьера организма назначают горячие напитки с повышенным содержанием витамина C. В этом случае отдается предпочтение: Отвар из плодов шиповника.
- Чай с дольками лимона.
- Компоты и морсы на основе черной смородины.
Производится ингаляции с добавлением в горячую воду уксуса.Хорошим эффектом обладает приготовленный домашний отвар на основе окопника, корней петрушки и сельдерея.Отвар из репейника (корни лопуха) можно закапывать в нос.Ежедневно можно совершать процедуру промывания полости носа отваром из соцветий ромашки или календулы.
Лечение
Терапия стафилококка представлена приемом сильных антибактериальных средств, как общего, так и местного действия. Ввиду большого риска возникновения осложнений лечение назначается специалистом после получения данных о морфологии возбудителя. Антибиотики, применяемые в лечении бактериальной инфекции носа и зева:
- Биопарокс-спрей – препарат местного действия, проникает со все слизистые слои, вызывая гибель бактериальной микрофлоры;
- Мупироцин-мазь – применяется с целью устранить инфекцию в носу и поверхностных слоев лица.
К средствам от стафилококка в носу общего действия относятся такие таблетированные препараты как:
- Офлоксацин;
- Амоксициллин;
- Цефтриаксон;
- Амоксиклав.
Лечение стафилококка в носу у взрослых антибиотиками осуществляется длительное время. Курс терапии устанавливается врачом. Прерывать прием антибиотиков недопустимо, иначе заболевание перейдет в хроническую форму, либо разовьются неблагоприятные осложнения.
Обратите внимание! Прием антибиотиков необходимо сочетать с пробиотиками – препаратами, которые восстанавливают баланс микрофлоры и препятствуют возникновению грибковых инфекций.
Помимо антибиотиков назначаются местные иммуномодулирующие капли, противовирусные препараты общего действия, антисептические растворы для промывания полостей носа (на основе соли), регенерирующую мазь от стафилококка в носу и витаминные комплексы. Некоторые специалисты рекомендуют «прижигать» очаги специальным метиленовым синим реактивом. Достаточно часто для устранения микробной инфекции стафилококкового генеза применяют противостафилококковый бактериофаг (иммуноглобулин, позволяющий остановить рост бактерий, и привести к разрушению клеточной стенки).
Стафилококк в носу при беременности и в педиатрии
Проявление стафилококка во время вынашивания ребенка вызывает затруднения, так как большинство препаратов с антибактериальным действием попадает под строгий запрет. Это связано с тем, что они могут отрицательно влиять на умственное и физическое развитие будущего малыша.
Особую осторожность следует соблюдать в первый триместр беременности.
Чтобы минимизировать негативное влияние на плод беременной женщине назначают:
- Раствор Хлорофиллипта.
- Обработку с помощью перекиси Водорода или Зеленки.
- Допускается применение метода иммунизации при помощи Стафилококкового анатоксина.
- Назначаются курс сеансов облучение кварцевой лампой.
У детей подросткового возраста терапия стафилококка в носу происходит по тем же принципам что и у взрослых пациентов. Существенная разница составляет в дозировке и кратности применения медикаментозного средства. Обычно доза сокращается вдвое. Отдельные препараты назначаются детям с учетом веса.
Особая осторожность нужна при назначении терапии самым маленьким пациентам грудного возраста. Для их лечения не применяют аппликации с лекарственными средствами (закладывание турунд). Кроме этого им не назначают спреи для назального применения.
Антибактериальные препараты назначаются в крайних случаях, с использованием минимальных доз. Из-за того что ребёнок не сможет проглотить таблетку их применение возможно только путём внутримышечной инъекции.
Мазок из носа и зева на стафилококк
Для диагностики недуга берут мазок из зева и носа на наличие патогенного бактерий, а также проводят анализ крови. Бояться исследования не стоит, ведь то, как берут образцы, не доставляет больному никаких болевых ощущений.
Для этого стерильной ватной палочкой проводят по внутренним поверхностям носоглотки. Смыв с нее высевают на питательные среды, то есть проводят анализ инвитро (в пробирке).
По истечении нескольких дней оценивают выросшие колонии по характеру краев и поверхности, величине, цвету и количеству, так как для каждого вида микроорганизмов характерно образование колоний со строго определенными параметрами.
Стоит отметить. Если посев из зева и носа показал стафилококк, сразу же лаборанты проводят оценку чувствительности обнаруженных микроорганизмов к различным антибиотикам.
Это крайне важно, поскольку сегодня из-за частого и необоснованного применения антибактериальных препаратов многие возбудители отличаются резистентностью (устойчивостью) к ним.
Поэтому, если нашли стафилококк, исследование позволяет сразу же определить, какое именно лекарство даст максимальный результат в каждом конкретном случае.
Каких ситуаций следует избегать, чтобы предотвратить развитие стафилококковой инфекции в носу?
Не допустить развитие стафилококка гораздо легче, чем приступать к его лечению.
Поэтому, как взрослому, так и ребёнку необходимо выполнять следующие рекомендации:
- В осенне-зимний период по возможности ограничить посещение мест с повышенной скученностью людей (общественный транспорт, супермаркеты и магазины).
- Взять за привычку по приходу домой в первую очередь вымывать руки с мылом, умывать лицо и промывать носовые ходы.
- Любые повреждения, которые связаны с открытой раневой поверхностью, обрабатывать антисептиками, а при необходимости налаживать стерильную повязку.
- Одеваться по сезону, не допуская, чтобы организм подвергался длительному переохлаждению.
- Овощи и фрукты обязательно должны хорошо вымываться перед едой, а мясо и рыба должны проходить полноценную термическую обработку.
- В квартире, хотя бы один раз в три дня, проводить влажную уборку.
Причины отчего появляется эпидермальный патогенный стафилококк
Бактерия стафилококк под микроскопом
В настоящее время существует множество видов стафилококка, некоторые из которых всегда присутствуют в организме человека, но не влияют на развитие заболеваний. Одним из таких считается эпидермальный золотистый стафилококк, он начинает свое действие при воздействии на организм определенных факторов. Поражает зачастую кожные покровы и слизистые участки. В основном причинами появления микроорганизма являются следующие:
- Нарушение правил личной гигиены — всем известно, что чистота считается залогом здоровья, потому что грязное тело и руки несут большое количество патогенных бактерий и микробов, в том числе стафилококк. Поэтому после посещения туалета, перед приемом еды необходимо тщательно мыть руки с помощью антибактериального мыла. Также следует следить за продуктами, овощи и фрукты желательно обдавать кипятком.
- Прямое заражение — происходит путем обычного рукопожатия, объятий, а также при пользовании чужих косметических принадлежностей или ношения не своей одежды.
- Чрезмерное употребление антибиотиков — пагубно сказывается на состоянии здоровья, может привести к проблемам с пищеварительной системой, дизентерии. Бесконтрольное употребление лекарственных препаратов в повышенных дозах может поспособствовать развитию стафилококковой инфекции. Поэтому перед употреблением таблеток, нужно консультироваться с врачом.
- Понижение иммунного статуса организма — главный фактор образования болезни горла и носа золотистым стафилококком. Оно может быть спровоцировано переохлаждением, наличием сопутствующей патологии, нервными перенапряжениями и отравлениями.
Заразен ли золотистый стафилококк и передаётся от носителя?
Стафилококк считается самым опасным возбудителем множества болезней и передается воздушно-капельным путем.
Основные профилактические мероприятия
Из-за того что вероятность развития этой болезни возрастает как следствие пониженного иммунного статуса, то мероприятиями которые помогут предотвратить этот патологический процесс должны быть направлены на повышение защитных сил организма.
С этой целью нужно выполнять следующие указания:
- Каждое утро начинать с проведения гимнастических упражнений, который лучше всего проводить с открытым окном. После этого, переходить к водным процедурам, применение которых позволить закалить организм. Изначально рекомендуется обтирание холодным полотенцем, или применение контрастного душа.
- Очень хорошо если трижды в неделю отводить время для занятия в спортзале или плавательном бассейне. Отсутствие такой возможности можно заменить ежедневными пешими прогулками.
- Необходимо следить, чтобы в ежедневном рационе присутствовали свежие овощи и фрукты. Особенно это актуально в зимний и весенний период, когда появляется симптоматика авитаминоза.
Любое проявление насморка, особенно если он сопровождается гнойными выделениями, не исключает развития стафилококка в полости носа. Игнорировать этот симптом недопустимо, так как быстрое прогрессирование болезни может вызвать негативную симптоматику и состояния, которые будут угрожать жизни пациента.
Кроме этого самостоятельное назначение рецептов народной медицины может повлечь тяжёлые последствия для больного. Нужно помнить, что применение лечебных трав имеет свои показания и противопоказания.
Причины возникновения
Стафилококк – это грампозитивный шарообразный микроорганизм, неспособный к передвижению. Микроб присутствует везде: он летает в воздухе, распространяется на поверхностях, проникает в воду и продукты питания.
Особенность бактерии заключается в повышенной устойчивости к антибактериальным препаратам. Несмотря на то, что стафилококк неподвижен, инфекция развивается стремительно, распространяясь с полости носа в нижние дыхательные пути. Усугубляет патологический процесс то, что микроб относится к условно-патогенным МКО. Активизация патологического процесса связана со снижением иммунитета, наличием микроцарапины слизистого слоя и усиленным размножением грамотрицательного микроорганизма.
Поражение стафилококком носовых ходов и полости происходит не следующим причинам:
- Снижение иммунитета на фоне общей респираторной вирусной инфекции. Такие заболевания как ринит, синусит, тонзиллит, фарингит угнетают иммунную систему, наблюдается снижение защитных сил организма, соответственно нарастает количество бактерий. Кроме того воспалительные процессы вызывают микроповреждения многослойного эпителия и выступают входными для инфекции воротами. Иногда снижение иммунитета не связано с заболеваниями ЛОР органов, а обусловлено переохлаждением организма.
- Несоблюдение стандартных правил гигиены – мытья рук после посещения туалета и прихода с улицы. Во время нестабильной эпидситуации, необходимо смывать с рук и лица патогенных агентов, используя мыло. Пренебрежение этого правила ведет к обсемененности стафилококком рта, носа и лица.
-
Длительный прием антибактериальных лекарственных препаратов для лечения болезней иного генеза. Антибиотикотерапия подавляет рост микрофлоры, в частности патогенной, но при частом и длительном применении развивается снижение местного иммунитета, нарушается баланс полезных МКО. Такое состояние создает оптимальные условия для размножения стафилококка.
- Непосредственное заражение от больного человека. Стафилококк передается контактно-бытовым и воздушно-капельным путем, то есть чих, рукопожатие, поцелуй и даже использование обще посуды приводит к заражению (но при условии сниженного иммунитета).
- Необоснованный или неконтролируемый прием иммунодепрессантов, а также состояние затяжного стресса или депрессивных расстройств.
- ВБИ – внутрибольничное инфицирование. Пребывание в стационаре детей и взрослых может закончиться инфицирование патогенного микроба, если в воздухе отделения установили повышенную концентрацию Staphylococcus.
- Иммунодефицит острого или хронического течения. Возникновение бактериальной инфекции в нос может быть связано с вирусом иммунодефицита человека.
Несмотря на разнообразие причин развития инфекции, основа недуга – падение защитных сил организма. Обуславливается этот факт тем, что возбудитель условно-патогенного происхождения.
В зону риска развития инфицирования входят дети, пожилые люди, беременные женщины, медицинские работники и пациенты с нарушениями эндокринной системы (диабетики).
Симптомы инфекции
Клиническая картина
Что говорят врачи о паразитах
Доктор медицинских наук, профессор Гандельман Г. Ш.:
Занимаюсь обнаружением и лечением паразитов уже много лет. С уверенностью могу сказать, что паразитами заражены практически все. Просто большинство из них крайне трудно обнаружимы. Они могут быть где угодно — в крови, кишечнике, легких, сердце, мозге. Паразиты в буквальном смысле пожирают вас изнутри, заодно отравляя организм. В итоге, появляются многочисленные проблемы со здоровьем, сокращающие жизнь на 15-25 лет.
Основная ошибка — затягивание! Чем раньше начать выводить паразитов, тем лучше. Если же говорить о лекарствах, то тут всё проблематично. На сегодняшний день существует только один действительно эффективный антипаразитный комплекс, это Toximin. Он уничтожает и выметает из организма всех известных паразитов — от головного мозга и сердца до печени и кишечника. На такое не способен больше ни один из существующих сегодня препаратов.
В рамках Федеральной программы, при подаче заявки до 12 октября. (включительно) каждый житель РФ и СНГ может получить одну упаковку Toximin БЕСПЛАТНО!
Узнать больше>>
Необходимо различать носительство стафилококка и стафилококковую инфекцию. Если анализ показал, что в носу есть стафилококк, но нет реальных симптомов болезни, то для беспокойства нет повода.
В таких ситуациях не нужно глотать антибиотики или пытаться вылечить себя другими медикаментозными средствами. Оптимальным шагом будет принятие мер по укреплению иммунитета. Сильному организму стафилококк не опасен.
Наоборот, при развившейся инфекции без лечения не обойтись. Стафилококковая инфекция – состояние, при котором бактерии активизировались и стали причиной заболевания носоглотки.
Последствия запущенной инфекции
Всевозможные ферменты, вырабатываемые патогенными бактериями, попав в кровь, могут привести к серьезным нарушениям в работе сердечно-сосудистой системы. Кроме того, проникнув в кровоток, бактерия разносится по всем уголкам. В результате может произойти формирование гнойных воспалительных очагов во внутренних органах.
Если в процесс вовлечены сердце или мозг, легочные ткани или почки, желудок с кишечником либо длинные кости, спасти жизнь человеку становится крайне сложно. В основном, это запущенные формы заболевания и вероятность летального исхода достаточно высока.
При значительном расширении площади пораженных зон возникают следующие характерные симптомы:
- суточный разброс колебаний температуры составляет от 2 до 3°С;
- выраженная слабость с усиленным потоотделением;
- резкое понижение артериального давления, чреватое комой;
- отдышка, потемнение в глазах, спонтанная потеря сознания.
При выявлении по итогам анализа опасной концентрации стафилококка, врач незамедлительно назначается больному курс лечения. Это могут быть антибиотики, бактериофаги, антисептики, иммуностимуляторы, витамины.
В запущенной стадии протекания болезни пациент будет помещен в стационар под наблюдение медиков.
Местное лечение от стафилококка в ротоносоглотке
Локальная борьба со стафилококком заключается в полоскании горла и рассасывании леденцов, которые содержат антисептики.
Специалисты рекомендуют полоскать горло такими средствами, как Хлорофиллипт, Тантум Верде, Хлоргексидин, Мирамистин или Гексорал, поскольку они обладают наивысшей эффективностью по отношению к золотистому стафилококку.
Перечисленные антисептики обладают противомикробным, противовоспалительным и восстанавливающим действиями, что позволяет уменьшить выраженность симптомов инфекции, ускорить выздоровление и предотвратить развитие серьезных осложнений.
Что нужно знать о стафилококке
Стафилококки — это разновидность грамположительных бактерий, обитающих в почве, воздухе и на предметах окружающей среды. Являются представителями нормальной микрофлоры человека и животных.
Среди стафилококков существует множество видов, оказывающих неоднозначное влияние на организм. Некоторые из них являются условно-патогенными, то есть не проявляющими себя до тех пор, пока не произойдет снижение иммунитета. Другие — изначально болезнетворны и способны оказать разрушающее действие на живые клетки.
В естественных условиях патогенные и условно-патогенные виды населяют носовую полость, горло и кожные покровы человека, но далеко не всегда провоцируют недуг.
Стафилококковая инфекция в носу и горле станет активной лишь тогда, когда превысит численностью нормальную микрофлору организма. В этом случае лечение должно быть быстрым и грамотным, поскольку кокки способны стремительно распространяться и поражать близлежащие органы и ткани.
Способы заражения
Заражение часто происходит в больницах, роддомах, салонах красоты, тату-салонах, если там не соблюдают санитарные нормы и требования.
Заразиться стафилококковой инфекцией можно:
- воздушно-капельными путями;
- используя личные предметы заболевшего;
- при внутриутробном развитии младенца, при родах, при кормлении грудным молоком;
- при употреблении испорченных или плохо обработанных продуктов питания;
- иногда при различных медицинских процедурах и инъекциях.
Наиболее подвержены стафилококковой инфекции дети, старики, беременные, люди со слабым иммунитетом. Больше всего подвергаются заражению люди, переболевшие герпесом и вирусной инфекцией Эпштейна Бара, цитомегаловирусом.
Опасность
Если патогенный микроб поселяется в носу, то у взрослых, либо у малышей могут возникнуть следующие осложнения:
- Воспаление развивается очень стремительно. Если своевременно не удастся купировать этот процесс, то он распространится сразу на дыхательные пути, а потом и на рядом расположенные органы. Используя лимфатический либо гематогенный путь, микроб может добраться до сердца, печенки и т. д.
- У многих людей изначально развивается ринит. Через время к нему присоединяются различные заболевания, например аденоидит, гайморит, ангина, отиты и т. д. У пациентов, которые имеют определенную предрасположенность, патогенный микроб может спровоцировать развитие трахеита, бронхита.
- У людей преклонного возраста и у малышей помимо вышеперечисленных заболеваний могут развиваться более тяжелые патологии: поражение сердца, почек, печенки, головного мозга, костей, развиваются абсцессы.
Формы
На сегодняшний день, выделяют несколько форм стафилококковой инфекции, самые распространенные из них это:
- Сапрофитовая – эта форма, считается наиболее легкой, в основном развивается в мочеполовой системе, может провоцировать такую болезнь, как цистит.
- Эпидермальная – данный вид является обитателем кожи человека и слизистых оболочек. При определенных условиях кокки начинают размножаться и проникают в кровь, становясь причиной развития воспалительных процессов в глубоких слоях кожи.
- Золотистая – наиболее тяжелый вид инфекции, может вызывать более 100 видов болезней, чаще всего развивается в желудочно-кишечном тракте и носовой полости, очень устойчив к лечению.
Можно ли заразиться стафилококковой инфекцией?
Стафилококк в носу – заразно ли это? Вопрос не совсем корректен, т.к. 8 из 10 человек уже имеют эту «инфекцию» в неактивной форме, а оставшиеся 2 человека обладают резистентностью к ней. Мы получаем стафилококки разными путями, среди которых наиболее частыми являются:
- Вдыхание воздуха с частицами пыли, в том числе домашней;
- прикосновения, обнимания, поцелуи – бактерии живут на коже лица, рук;
- занятие оральным сексом (в активной роли) – золотистый стафилококк очень любит паховую область;
- употребление термически необработанной пищи (кипячение уничтожает стафилококк).
Таким образом, получить стафилококк не представляет труда. Беспокоиться на эту тему не следует. Избежать «заражения» невозможно. Условно-патогенный статус бактерии делает ее не опасным постоянным обитателей наших носов.
Актуальнее другой вопрос:
Почему стафилококк, постоянно или эпизодически «проживающий» в носу, иногда вдруг переходит в патогенную фазу с развитием полноценного инфекционного процесса?
Причина всего одна – иммунноугнетенное состояние, возникающее на фоне вирусной инфекции.
Особенностью всех вирусов, включая то, что называется «простудой», является их способность подавлять иммунитет, блокируя выработку иммунными клетками интерферона. Они делают это для того, что иметь возможность проникать в здоровые клетки организма и запускать в них процесс саморепликации. Угнетенным состоянием иммунитета пользуются бактерии, в том числе золотистый стафилококк. Они проникают глубже в слизистые, дальше по дыхательным путям, могут оказаться в среднем ухе.
Таким образом, вирусная инфекция является тем катализатором, который может повлечь переход стафилококка из условно-патогенного состояния в патогенное и вызвать стафилококковую инфекцию в носу.
В случаях локализации инфекционного процесса в носу в этом виноваты следующие вирусы:
- Все респираторные вирусы (ОРВИ, грипп и прочие);
- вирус герпес как один из самых иммунноугнетающих;
- вирус иммунодефицита.
Микроскопическое исследование
Собранный биоматериал помещают в стерильные колбы, содержащие специальный раствор, продлевающий жизнь бактериям. На дальнейшие манипуляции с биоматериалом отводится не более 3 часов.
Посев исследуемого материала
В биоматериале, собранном со слизистых, очень сложно обнаружить небольшое количество стафилококков и любых других микроорганизмов. Для изучения степени биологического заражения отделяемого проводят его посев в чашку Петри на особую питательную среду – кровяной агар, который обеспечивает питание, дыхание, рост и размножение стафилококков.
В агаре микроорганизмы активно делятся, образуя колонии, видимые невооруженным глазом. Мазок засевают в чашки Петри и помещают в термостат. Через несколько суток на питательной среде образуются колонии различной формы, размера и цвета. Их переселяют на специализированные питательные среды, чтобы выделить и накопить чистую культуру.
Размножившиеся микроорганизмы идентифицируют, определяя их род и вид, проводят фаготипирование и серотипирование. Для окончательного микроскопирования материал берут из чашки Петри стерильной петлей, фиксируют на предметном стекле и окрашивают по Грамму.
Таблица: определение микробного состава мазка
| Микроорганизм | Вид под увеличением |
| Стафилококки | Колонии в виде виноградной грозди |
| Стрептококки | Парно расположенные кокки или Цепочки из шарообразных бактерий, положительно окрашенных по Грамму |
| Нейсерия | Присутствие на предметном стекле единичных грамотрицательных кокков |
| Клебсиеллы | Грамотрицательные бактерии с закругленными кончиками |
| Эшерихии и синегнойные палочки | Неокрашенные палочкообразные образования небольшого размера. |
Для постановки диагноза решающее значение имеет не столько обнаружение в исследуемом материале отдельных бактерий золотистого стафилококка и других микроорганизмов, сколько количественная оценка роста колонии микроорганизмов.
Таблица: Расшифровка роста микробных колоний
Очень скудный рост до 10 Скудный рост 10-25 Умеренный рост до 50 Обильный рост Количество колоний трудно или невозможно сосчитать
Норма стафилококка в мазке из зева
Для расшифровки результата исследования на бактерий семейства Staphylococcaceae нужно понимать, о чем говорят основные цифры, проставленные на бланке исследования. Обычно в первой колонке указывают вид микроорганизма. Врача в первую очередь будут интересовать, обнаружены ли в мазке Staphylococcus aureus и Staphylococcus saprophyticus. Во второй колонке проставляют количество микроорганизмов в КОЕ/мл.
КОЕ – это стандартный показатель, указывающий на число бактерий в одном миллилитре питательной среды.
Нормальным для взрослого считается количество микробов до 103 КОЕ/мл. Этот показатель говорит о естественности микрофлоры. У ребятишек до 12 месяцев нормальным считается содержание бактерий до 104 КОЕ/мл.
Показатели выше этих значений говорят о том, что воспаление в горле вызвано микробным заражением. Современные клиники проводят исследование чувствительности штаммов стафилококка к следующим антибиотикам:
- пенициллинам;
- тетрациклинам;
- эритромицинам;
- цефалоспоринам.
Исследование на резистентность выявленного штамма проводится в короткие сроки с помощью специальных лабораторных тестов. Оно необходимо в ряде сложных случаев, так как позволяет эффективно подобрать медикаменты для лечения больных.
Сдача анализов на бакпосев
Если возникает подозрение, что в теле развивается стафилококк, в первую очередь, не надо паниковать.
Существует множество современных препаратов, таких как Альфа Нормикс, которые свободно справляются с инфекцией. Нужно лишь обратиться к врачу, чтобы он осмотрел и в случае необходимости назначил анализы.
Для точного определения, стафилококк ли является возбудителем заболевания, у больного берут на исследование биоматериалы. Это может быть кровь, содержимое гнойничков, отходящая мокрота, а в некоторых ситуациях и спинномозговая жидкость.
Значимые показатели анализа – выявление в сыворотке крови антител к антигенам стафилококка. Для этого используют реакцию торможения гемолиза, реакцию пассивной гемагглютинации. Одновременно проверяется чувствительность бактерии к различным противомикробным препаратам, чтобы в последующем сделать правильный выбор лекарства для борьбы с ним.
В случае если человек относится к группе пациентов с повышенным риском стафилококковой инфекции (из-за перенесенных заболеваний, других причин, вызвавших ослабление иммунной системы), врач может рекомендовать прохождение быстрого теста на коагулазу. Такое тестирование – надежный способ определения кокков в крови. Если он покажет положительный результат – значит возбудителем стал золотистый стафилококк, если отрицательный – эпидермальный или сапрофитный.
Чего стоит избегать?
- Греть область носа
При насморке, гнойном отделяемом из носа нельзя греть переносицу, область лба и щек (надчелюстную область). Тем более, если в упомянутых локализациях имеется болевое ощущение.
- Перегревать организм
Следует избегать не только локального перегрева, но и общего: нельзя принимать горячий душ или ванну, посещать парные или сауны.
- Переохлаждаться
Также как перегрев, вредно и переохлаждение. Если нагрев стимулирует ускоренное размножение бактерий, то переохлаждение как общее, так и отдельных частей тела (напр., ног, головы) ведет к ослаблению иммунитета и, следовательно, к снижению сопротивляемости организма дальнейшему распространению бактерий.
Что нельзя делать больному?
Существует ряд противопоказаний:
- запрещено прибегать к согревательным процедурам;
- нельзя прогревать носоглотку, использовать компрессы;
- необходимо исключить из питания мед, молочные продукты, соки;
- нельзя санировать полость носа спиртосодержащими веществами;
- запрещено самостоятельно вскрывать гнойники возле носа.
Тепло, сладости, молочные продукты – благоприятный фактор для разнесения патогенных бактерий по всему организму, их размножения, увеличения гнойничков.
Золотистый стафилококк устойчив к спирту, спиртовые растворы сушат слизистую.
Последствия
Если терапия стафилококка проведена не в полной мере или не оказала должного эффекта, возможно развитие хронической формы заболевания и появление осложнений. Все виды стафилококка опасны для организма, но особо угрожающе ведет себя золотистая бактерия.
Возбудитель способен вызвать поражение легких, мозга и крови. Длительные изъязвления слизистой и кожных покровов заканчиваются появлением рубцов и шрамов.
При неграмотной терапии стафилококковой инфекции развиваются серьезные осложнения
Стафилококковая инфекция в носу зачастую становится причиной гайморита, фронтита, острого ринита и даже отита среднего уха. Запущенный воспалительный процесс нередко провоцирует атрофию слизистой и полную или частичную потерю обоняния.
Особенно зловреден внутрибольничный стафилококк. Огромная колония бактерий настолько быстро мутирует, что уничтожить ее становится очень трудно. Микроорганизмы спокойно переносят прямые солнечные лучи, выдерживают длительное кипячение и обработку спиртом.
Патогены, проникшие в кровяное русло, способны вызвать эндокардит, заражение крови, сепсис, патологии опорно-двигательного аппарата. Именно стафилококк становится виновником подросткового артрита. Проникновение бактерии в ЦНС заканчивается абсцессами и внутричерепными осложнениями.
Общие схемы лечения
Терапия должна назначаться исключительно врачом. Самолечение может привести к тому, что стафилококк выработает собственный иммунитет к препаратам, что усложнит процесс дальнейшей борьбы с ним.
Медикаментозная терапия
Медикаментозное лечение включает в себя следующие группы препаратов:
- подобранные в лаборатории антибиотики, среди препаратов выбора: Цефалексин;
- Ципрофлоксацин;
- Амоксиклав;
- Ко-тримоксазол;
средства для иммуномодуляции:
Бронхомунал;Деринат;витамины и минералы:
Витамакс;средства против аллергии, которые способствуют снятию отёка:
Зодак.
Кроме этого, врач назначает лечение недугов, которые развились вследствие стафилококковой атаки.
Приём антибиотика — один из самых важных элементов лечения. Если препарат будет неверно подобран или назначена его неправильная дозировка, то осложнений не избежать. Состояние больного будет отягощаться. Может развиться вторичная инфекция.
Для усиления эффекта назначенного лечения советуют использовать следующие средства:
- растворы антисептиков для промывания полости носа: Фурацилина;
- Диоксидина;
- Мирамистина;
- Хлоргексидина;
сосудосуживающие капли или аэрозоли для полости носа, обладающие антибактериальным эффектом:
Септисол;ИРС-19;антибактериальные мази при появлении в носу гнойников:
Эритромициновую;Банеоцин;Фузидин;перекись водорода 3%, которую разбавляют водой в пропорции 1:10, для промывания носа;капли на масляной основе:
Пиновит.
Стоит учитывать, что гнойники больших размеров вскрываются путём хирургического вмешательства.
Для предупреждения инфицирования глотки проводят процедуры полоскания фурацилиновым раствором.
Со стафилококковой инфекцией в носу мне пришлось столкнуться, когда у дочки мы в течение двух месяцев не могли вылечить насморк. Отделяемое было очень густое и даже не зелёного, а жёлтого цвета. Сдав мазок из носа, мы узнали, что имеем дело со стафилококковой инфекцией. В нашем исследовании сразу было уточнено, к каким антибиотикам чувствительна бактерия. Одним из компонентов лечения, которое нам назначил врач, была Тетрациклиновая мазь. Ею мы просто смазывали слизистую носа при помощи ватной палочки трижды в день. От насморка мы наконец-то избавились. Я рада, что за время поисков причины у нас не случилось осложнений, ведь золотистый стафилококк — очень опасная инфекция.
Фотогалерея: препараты для лечения стафилококковой инфекции в носу
Иммунал (Immunal) – растительный лекарственный препарат, обладающий противовирусным, противовоспалительным, иммуностимулирующим свойствами
Алфавит — витамины, максимально обеспечивающие всеми необходимыми веществами
Цетрин — противоаллергический препарат
Мирамистин обладает широким спектром антимикробного действия
Изофра — антибиотик для местного применения
Банеоцин — препарат с антибактериальным действием для наружного применения
Перекись водорода — антисептическое средство
Пиносол — препарат с противомикробным и противовоспалительным действием для местного применения в ЛОР-практике
Народные рецепты
Этим недугом люди страдают уже так давно, поэтому появились народные методы борьбы с ним, которые зарекомендовали себя с положительной стороны. Но эти способы не могут заменить терапии, назначенной врачом, и способны лишь облегчить состояние больного.
Итак, в условиях дома можно воспользоваться следующими видами помощи:
- Паровыми ингаляциями. В закипевшую воду добавляют яблочный уксус (1:1). Пары раствора необходимо вдыхать 2 минуты.
- Компрессами. Используют для уменьшения гнойных выделений. Чтобы приготовить компресс, надо использовать настой окопника: 4–5 ст. л. окопника лекарственного заливают 250 мл крутого кипятка.
- Дают остыть.
- Смачивают настоем ватные турунды и вставляют их в носовые ходы на 10 минут. Компрессы делают от 4 раз в сутки.
Закапыванием. В качестве капель используют настой корней репейника:
Настаивают 30 минут.После полного остывания закапывают по 2–3 капли в каждую ноздрю.Промыванием. Изготавливают отвар из цветков ромашки. Им проводят процедуру полоскания горла, промывания носоглотки, принимают внутрь:
2 ст. л. заливают 250 мл кипятка, проваривают на паровой бане в течение 3–5 минут.Дают остыть и настояться не менее часа.Перед употреблением отвар процеживают.Полосканием. Применяется календула. Цветки календулы заваривают и используют для полоскания:
Отвар готовят на паровой бане 3–5 минут, затем настаивают около часа.Процеженным отваром производят полоскание горла. Жидкость должна быть тёплой.
Также, используя народные рецепты, можно поднять иммунитет. Применяют:
- настойку эхинацеи (в аптеке продаётся готовый препарат, применяют его согласно инструкции);
- отвар шиповника два раза в день по полстакана (2 ст. л. толчёных ягод на 400 мл кипятка томят на водяной бане 20 минут, настаивают и процеживают перед употреблением).
Фотогалерея: компоненты народных рецептов от стафилококковой инфекции
Окопник — природный антибиотик
Отвар корня репейника укрепляет местный иммунитет
Настой цветков ромашки обладает противовоспалительным и антисептическим свойствами
Препараты календулы оказывают бактерицидное действие на ряд опасных микроорганизмов, включая стрептококки и стафилококки
Отвары шиповника укрепляют иммунитет
Общеукрепляющие и тонизирующие свойства эхинацеи достигаются за счёт наличия антиоксидантов — эхиноцина, эхинолона
Физиотерапия в лечении золотистого стафилококка
Главной целью физиотерапии в лечении стафилококковой инфекции является стабилизация и регресс воспалительных процессов.
При заболевании носоглотки из-за поражения золотистым стафилококком назначаются физиотерапевтические процедуры, такие как:
- КУФ в нос (лечение короткими волнами ультрафиолета, которые обладают бактерицидным и противовирусным свойствами) — помогает окончательно убирать микроорганизмы, частично восстанавливая слизистую;
- ингаляции с Диоксидином, спиртовым раствором Хлорофиллипта — оказывают антибактериальный эффект, не давая увеличиваться колонии золотистого стафилококка.
Противопоказания к процедурам
Физиотерапевтические процедуры нельзя проводить в стадии обострения, когда выделения из носа гнойные. Прогревание и пар показаны только на завершающей стадии выздоровления, когда выделения из носа приобретают прозрачность.
Видео об особенностях лечения золотистого стафилококка в горле у детей
Получая на руки результаты анализа на микрофлору, многие видят в них слово «стафилококк». Стоит ли тревожиться, если при этом симптомы инфекции отсутствуют? Передастся ли бактерия от мамы-носителя ребенку, и обязательно ли он заболеет после этого? Эти вопросы волнуют родителей. Нередко взрослые, получив положительный анализ на стафилококк, начинают лечиться непонятно от чего. В предлагаемом видео доктор Комаровский расскажет о бактериях-возбудителях инфекции, о стафилококковой ангине у детей, и лечении малышей.
Как передается
Стафилококк — Школа доктора Комаровского
Стафилококковая ангина
Народные средства от стафилококка
Применение народных средств для лечения стафилококка в носу имеет смысл исключительно с целью иммуностимуляции. Без антибиотического лечения все народные средства будут неэффективны.
Среди растительных иммуностимуляторов следует, прежде всего, отметить экстракт элеутерококка. Это – адаптаген природного происхождения. Приобретается в аптеках безрецептурно.
Традиционно к растениям с иммуностимулирующим действием относят:
- Эхинацея (цветы);
- шиповник (плоды, цветы);
- зверобой (листья, цветы);
- боярышник (плоды, цветы, корни).
Из сырья перечисленных растений делают настои (моно или из нескольких трав) из расчета 1 ст. л. на 200 мл воды. Принимают внутрь по 100 мл. 2 раза в день.
Профилактика
Стафилококк настолько устойчив, что даже при грамотном и своевременном лечении избавиться от него с первого раза удается далеко не всегда. Зачастую требуется несколько курсов антимикробной терапии разными препаратами. Поэтому проще не допустить заболевание, чем потом долго и трудно бороться с ним.
К основным мерам профилактики относят:
- своевременное устранение всех воспалительных процессов в организме;
- соблюдение личной гигиены, регулярная влажная уборка помещений;
- ведение здорового образа жизни, укрепление иммунитета.
Замечено, что человек с высокой защитной реакцией организма меньше подвержен риску развития стафилококковой инфекции.
При первых признаках снижения иммунитета следует немедленно начать принимать лекарства, повышающие резистентность организма. Кроме того, рекомендуется изменить режим дня, свести к минимуму стрессы и физические перегрузки, сбалансировать питание. Главное — не дать стафилококку в носу шансов на рост и развитие.
Диагностика
Прежде чем приступать к лечению, необходимо проведение качественной диагностики. Основной анализ, который используется во врачебной практике при подозрении на наличие патогенной бактерии – их выделение при помощи бактериального посева. Однако пациенту будет необходимо к исследованию подготовиться, чтобы получить максимально достоверный результат.
Во-первых, в этот день следует отказаться от использования любых капель для носа. Во-вторых, не проходить лечение любыми антибактериальными средствами, как минимум, неделю. Единственный недостаток этого метода заключается в том, что результата придется ждать, как минимум, пять дней.
Если диагноз требуется выставить быстрее, то на помощь приходит микроскопический метод анализа мазка. Но в отличие от него культуральный метод исследования, а именно, бакпосев позволит не только уточнить полученные данные, но и выявить конкретный вид бактерии, а также дополнить сведения антибиотикограммой.
После того, как результаты получены и в носу были выявлены стафилококки в количестве превышающей максимальную отметку в 106 единиц, необходимо приступать к лечению.
Разновидности анализов на стафилококк, как сдать правильно
Стафилококковая инфекция опасна для организма человека, может привести к серьезным осложнениям и даже гибели, поэтому важно выявить ее как можно раньше. В каждом конкретном случае врач может назначить различные исследования
Основными являются:
- анализ кала или мочи;
- грудного молока;
- мазки со слизистых оболочек;
- анализ крови, гнойных масс, различных отделений.
Чтобы получить оптимально правильный результат, анализы должны быть сделаны чисто. Пациент должен правильно подготовиться к сбору материала для анализов. Некоторые из них может брать только специалист в условиях лаборатории, некоторые можно взять самостоятельно дома.
К сдаче каждого анализа требуется специфическая подготовка, но есть несколько общих правил:
- за несколько дней до исследования следует прекратить прием противовирусных препаратов и антибиотиков;
- женщинам необходимо сдавать кал, мочу и мазки за несколько дней до менструаций или через 2-3 дня после;
- не желательно употребление алкоголя за день до исследований;
- активные физические нагрузки и занятия спортом лучше исключить за 1-2 дня до исследования.
Анализ кала
Делается при поражениях желудочно-кишечного тракта.
Перед тем как сдавать кал, нельзя применять слабительные средства.
Кал должен быть собран в специальный контейнер при помощи специальной ложечки (продается в аптеке в комплекте). Если используете другую емкость, ее необходимо стерилизовать, например, паром. Необходимо заполнить контейнер примерно на треть.
Нельзя собирать материал из унитаза, чтобы посторонние микроорганизмы не попали на образец для анализа.
Бактериальный посев мочи
Покажет наличие инфекции в мочевыводящих путях. Контейнер необходимо использовать стерильный, желательно приобретенный в аптеке. Перед мочеиспусканием хорошо вымыть половые органы чистой водой.
Собрать в контейнер среднюю порцию — сначала помочиться в унитаз, потом в контейнер и остаток снова в унитаз. При этом желательно процесс мочеиспускания не прерывать.
Анализ крови
Анализ подтвердит наличие бактерии в крови. Назначается при поражении различных органов, чаще всего легких, печени, головного мозга, нервной и костной систем. Этот анализ сегодня является самым надежным и быстрым в диагностике стафилококковой инфекции.
Процедура выполняется специалистом в медицинском учреждении. Любой анализ крови следует делать с утра и натощак для получения чистого результата.
Исследование грудного молока
Важный анализ, позволяющий выявить не только поражение молочных желез женщины, но и исключить заражение грудного ребенка.
Молоко левой и правой грудных желез должно быть собрано в разные стерильные контейнеры, пометив их. Предварительно нужно хорошо вымыть руки и молочные железы.
Первую порцию молока сцеживают в раковину, затем моют руки и молочные железы, насухо вытирают чистым полотенцем и только после этого приступают к сбору анализа. Из каждой груди нужно сцедить примерно 15 мл молока, закрыть контейнеры и быстро доставить материалы в лабораторию.
Правильный результат будет получен, если исследование материала провести не позднее, чем спустя 3 часа с момента сцеживания.
Мазки со слизистых оболочек, мокрота
Покажут картину распространения вируса в носоглотке. Ответственность за взятие этого материала ложится на медицинского работника, так как мазки и мокроту берут непосредственно в медицинском учреждении.
Пациенту не следует беспокоиться, предварительная подготовка заключается лишь в отказе от воды и пищи в течение 8 часов до исследования. Перед походом в больницу нельзя чистить зубы, полоскать рот, сморкаться, принимать лекарства. Процедура безболезненная и быстрая. Мазок берется ватной палочкой и помещается в специальную пробирку.
Урогенитальные мазки
Дают возможность проверить репродуктивную систему женщин и мужчин. Берутся на приеме у гинеколога или уролога. При сдаче мазка у женщин необходимо учитывать менструальный цикл.
Изучение гнойных выделений
Чаще всего от инфекции страдают кожные покровы. Данный анализ покажет наличие поражения стафилококком.
Материал для анализа собирает медицинский работник. Анализ берется с открытых гнойных ран при помощи стерильного ватного тампона, после удаления верхнего слоя раневого налета. Из закрытых гнойных нарывов материал берут при помощи шприца.
Методы лечения
Специалисты предпочитают лечить стафилококковые инфекции посредством антибиотиков. Для каждого пациента индивидуально разрабатывается схема, так как врачи учитывают возрастную категорию, тяжесть течения патологии и другие сопутствующие факторы.
В том случае, когда золотистый микроб был обнаружен в носу, больным прописываются следующие медикаментозные препараты:
- Таблетки «Флемоклава», «Амоксиклава».
- Таблетки «Цефалотина», «Цефалексина», «Азитромицина», «Эритромицина», «Ванкомицина».
- В том случае, когда назначенные антибиотики не смогли справиться со стафилококковой инфекцией, специалисты проводят корректирование медикаментозных схем. При наличии опасности развития серьезных осложнений пациентам прописывается лекарство «Анатоксин», либо иммуноглобулин антистафилакокковый. Благодаря этим медикаментам удастся купировать процесс развития интоксикации. Также специалисты могут прописать больным бактериофаги антистафилакокковые.
Чем лечить стафилококк на коже
Бактериальные инфекции поддаются терапии только с помощью антибиотиков, к которым они чувствительны. Стафилококк на коже устраняется преимущественно местными препаратами в форме мазей и кремов. При обширном поражении тканей и обнаружении микробов в крови могут быть назначены и системные средства. Иногда требуется оперативное вмешательство, когда обнаружен золотистый стафилококк на коже – лечение хирургическими методами рекомендуется в случае фурункулов, карбункулов и флегмоны.
Параллельно с базовой осуществляется иммуностимулирующая, противогрибковая и симптоматическая терапия:
- витамины;
- лакто- и бифидобактерии;
- противомикозные;
- обезболивающие;
- противовоспалительные.
Мазь от стафилококка на коже
В качестве местных препаратов подбираются медикаменты с широким спектром антибактериальной активности. Это помогает предотвратить развитие смешанной инфекции. Стафилококк на коже лица лучше лечить кремами, они быстрее впитываются и менее комедогенны. Эффективные противомикробные средства:
- Супироцин;
- Бактробан;
- Мупироцин;
- Бондерм;
- Фузидин;
- Банеоцин;
- Альтарго;
- Гентамицин и другие.
Препараты от стафилококка
Генерализованные поражения предполагают комплексную терапию, включающую внутренний прием медикаментов. Системный антибиотик от стафилококка на коже должен подбирать только специалист в соответствии с результатами анализов биологического материала. Самостоятельно приобретать и применять противомикробные препараты опасно, это чревато развитием суперинфекции. В таких ситуациях появляется стафилококк на здоровой коже, распространяясь на обширные участки эпидермиса.
Действенные системные антибиотики:
- Ванкомицин;
- Амоксициллин;
- Цефазолин;
- Клоксациллин;
- Цефалексин;
- Эритромицин;
- Оксациллин;
- Цефотаксим;
- Кларитромицин;
- Цефалотин;
- Клиндамицин и другие.
Лечение стафилококка народными средствами
Альтернативные способы терапии допускаются к использованию исключительно с разрешения доктора. Некоторые натуральные препараты помогают устранить стафилококк на коже – лечение с помощью народных рецептов обеспечивает удаление гнойных масс и качественную дезинфекцию поврежденного эпидермиса. Самый простой вариант – прикладывание к высыпаниям свежих и предварительно размятых листьев лопуха или салфетки, пропитанной яблочным уксусом (2 ст. ложки на 1 стакан воды). Компрессы следует менять каждые 4-5 часов.
Лечебная ванна от стафилококка
Ингредиенты:
- трава череды – 0,5 кг;
- вода – 3 л;
- эфирное масло чайного дерева – 10-20 капель.
Приготовление, применение:
- Вскипятить воду.
- Добавить в нее череду и уменьшить интенсивность огня.
- Потомить раствор 15 минут.
- Оставить средство до полного остывания под крышкой.
- Процедить жидкость, смешать ее с эфирным маслом.
- Набрать ванну, добавить в воду полученное лекарство.
- Полежать 15 минут.
- Кожу промокнуть полотенцем, не ополаскивая.